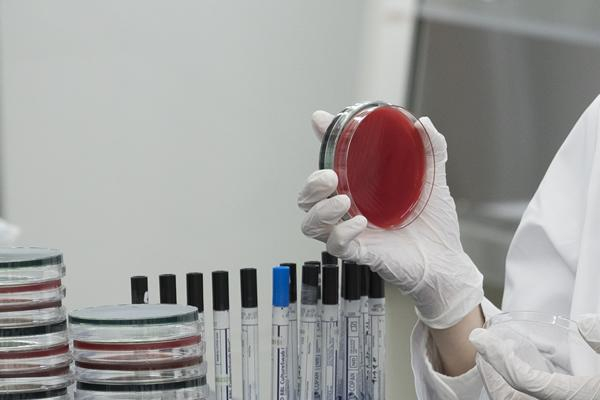

このコンテンツは獣医療従事者向けの内容です。
細菌感染症における抗菌薬治療では、原因菌の特定と薬剤感受性に基づいた適切な抗菌薬の選択が重要です。しかし、培養検査や感受性試験の結果が得られるまでには数日を要するため、臨床現場では結果を待たずに経験的な投薬が求められることも少なくありません。
経験的抗菌薬選択の一助とすべく、弊社の検査センターで実施された犬と猫の細菌培養検査結果を基に、部位別に分離された菌の傾向や耐性菌の現状についてお伝えします。
同一の採取部位であっても、犬と猫では分離頻度の上位の細菌が異なりました。
これは既に発表されている他国における報告と一致します(Nocera et al., Animals vol. 11, 6 1603. 2021)。
違いが生じる理由としては、犬と猫の常在菌の違いなどが考えられます。
尿から最も多く分離された菌は、犬猫ともにEscherichia coli:大腸菌 (犬38%、猫32%)でした。大腸菌の他にも、Proteus mirabilis、Enterococcus faecalis:腸球菌、Klebsiella pneumoniae:肺炎桿菌といった腸内細菌科に属する菌が多く分離されました。


皮膚では、犬猫共に、ブドウ球菌属の検出が多くみられましたが、犬ではStaphylococcus pseudintermedius(45%)が最も多く、次いでS.schleiferi(15%)が、猫ではS.aureus(16%)が最も多く、次いでS. pseudintermedius(14%)という結果になりました。
また猫では、Pseudomonas aeruginosa:緑膿菌 (8%)も分離されました。


皮膚と同様にブドウ球菌属が上位を占めましたが、皮膚とは傾向が異なり、犬で高率にP. aeruginosa:緑膿菌(20%)が分離されました。


犬と猫で特に一致率が低い結果となりました。


犬猫ともにE. coli:大腸菌 (犬39%、猫62%)が最も多く分離されました。


犬ではE. coli:大腸菌 (36%)が多く、猫ではBacteroides pyogenes(25%)をはじめ、Fusobacterium sp.やActinomyces sp.などの偏性嫌気性菌もみられました。


薬剤耐性菌の存在は、臨床における重要な課題と言えます。
今回は、犬と猫の尿・皮膚・耳検体におけるS. pseudintermediusのメチシリン耐性率と、尿検体におけるE. coli :大腸菌およびK. pneumoniae:肺炎桿菌のESBL産生率について比較しました。
① S. pseudintermediusのメチシリン耐性率(尿・皮膚・耳)
- 尿では、犬の方が有意に高い耐性率を示しました(P < 0.01)。
- 皮膚では尿とは反対に、猫の耐性率が犬を大きく上回りました(P < 0.01)。
- 耳では、動物種間では有意差は見られませんでした。
今回の検討からは、これらの差異についての明確な理由はわかりませんが、犬と猫で検出数に差があるために、そのバイアスが生じている可能性があるほか、それぞれの病態の違いや、選択される抗菌薬の種類や剤形の違いが影響している可能性が考えられます。
② E. coli :大腸菌およびK. pneumoniae:肺炎桿菌のESBL産生率(尿)
- E. coli :大腸菌では、犬猫で有意差はありませんでした(P = 0.51)。
- 一方、K. pneumoniae:肺炎桿菌では、猫のほうが明らかに高い耐性率を示しました(P < 0.01)。
今回の結果に限らず細菌検査の結果を読む上で、以下の点に注意する必要があります。
- 分離菌が必ずしも起因菌とは限らない
常在菌や汚染菌が分離される可能性があるため、特に皮膚や耳といった常在菌が多い部位では注意が必要です。無菌部位(血液、腹腔内液など)を除き、鏡検結果や臨床症状と照らし合わせる必要があります。 - 抗菌薬選択の際は経験的治療とデータの活用を統合する
グラム染色や好中球の貪食像、培養結果、今回のようなデータを総合的に活用しながら、初期治療の経験的抗菌薬選択を進めることが望ましいです。 - 耐性菌の動向を注視し、慎重に治療対応を行う
緑膿菌やESBL産生菌やメチシリン耐性ブドウ球菌など、薬剤耐性を示し治療が難しい菌が存在します。抗菌薬の濫用を避けつつ、必要な場合には細菌培養同定・感受性検査を行い、適切な薬剤を選択する必要があります。
今回のデータは、犬と猫の感染症治療を考える上で、部位別や動物種別の細菌分布の違いを改めて示すものとなりました。多くの部位では、動物種ごとに分離菌の傾向が異なり、抗菌薬の選択に際してもこの違いを認識することが重要です。さらに、耐性菌の増加、特にESBL産生菌やメチシリン耐性菌といった多剤耐性菌の存在は、今後の獣医療において注視すべき課題です。
私たちは裏方の立場ではありますが、引き続き最新の動向や知見を発信することで、臨床現場の先生方のお役に少しでも立てれば幸いです。
- 対象:
- 富士フイルムVETシステムズに細菌培養同定検査を依頼された犬・猫
- 期間:
- 2021年4月~2022年3月
- 地域:
- 日本全国
- 採材容器:
- 好気・嫌気両用 滅菌スワブ(チャコール加アミーズ培地)
- 細菌同定方法:
- マトリックス支援レーザー脱離イオン化飛行時間型質量分析法(MALDI-TOF MS)
- S. pseudintermedius のメチシリン耐性およびE. coli , K. pneumoniae のESBL産生有無判定基準:
- CLSI M-100 S-26
- 統計解析:
- フィッシャーの正確確率検定(有意水準 P < 0.05)
本コラムは、日本獣医臨床病理学会 2023年次大会 一般演題にて発表した内容を元に作成しています。
コマーシャルラボにおける採取部位別分離菌の集計結果報告
坂本芽以1)、大山幸宏1)、佐竹主税1)、玉本隆司1)、原田和記2)
- 1)富士フイルムVETシステムズ株式会社
- 2)鳥取大学農学部共同獣医学科 臨床獣医学講座